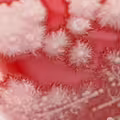
感冒秒吞抗生素！36歲男喉嚨痛　一照「長滿雪花」醫嚇愣

《一拳超人》主角埼玉是所有漫畫中最著名的硬幹型英雄之一,沒有任何超能力的他,只是個把當英雄作為興趣的普通人,憑藉連續3年每天進行長跑10公里、100下伏地挺身、100下仰臥起坐、100下深蹲的魔鬼訓練,最終獲得誇張的最強力量,不過也因為高強度的特訓掉光頭髮,「我禿了,也變強了」成為原著中最經典的台詞。

圖片來源 / 翻攝自バンダイチャンネル
根據媒體《香港01》、《東森新聞》的報導,中國網紅「堂主lee」在2022年8月發下豪語,稱要效仿《一拳超人》主角埼玉的訓練方式,進行為期1000天的嚴酷鍛鍊,並每天上傳訓練過程。

圖片來源 / 翻攝自遊民星空

圖片來源 / 翻攝自大眾視頻
然而一開始網上並沒有人看好堂主lee的挑戰,影片觀看數寥寥無幾,但他仍堅持不懈,直到訓練至259天時,他的影片點閱數和粉絲訂閱數突然有了爆炸性起色,第999天的點閱數更是飆破390萬,最後他在今年7月達成1000天的目標。

圖片來源 / 翻攝自西瓜視頻,下同

為了慶祝達成長達3年挑戰,堂主lee加碼將訓練量x10,各做了1000下伏地挺身、仰臥起坐與深蹲,甚至花12小時跑100公里,並在最後秀出全身的精實肌肉,還剃了個大光頭,直接穿上埼玉的英雄服,呼應「我禿了,也變強了」的金句。

圖片來源 / 翻攝自嗶哩嗶哩 (@堂主lee),下同

「堂主lee」的壯舉驚豔全網,連《一拳超人》的原作者ONE也在社群發文恭喜,「聽說中國有人完成了1000天的一拳超人訓練,好堅強的意志啊!恭喜!」

圖片來源 / 翻攝自X